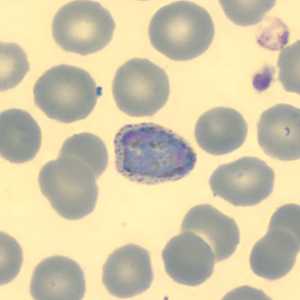
Case323_F
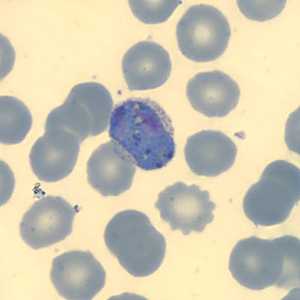
Case323_I

Case #323 - May, 2012
A 50-year-old man from Cambodia was admitted to the hospital for recurrent fevers. Blood specimens were collected in EDTA and sent to Hematology for routine work-up. Figures A-E show what was observed on a thin smear stained with Wright-Giemsa. The case was originally reported as Plasmodium falciparum and the patient was treated accordingly. One month later, the patient returned to the hospital, again with recurrent fevers. There was no documented international travel between hospital visits. A second blood specimen was collected in EDTA and sent to Hematology for work-up. Images F-I show what was observed on a thin smear stained with Wright-Giemsa. After the second examination, digital images from both collection dates were sent to DPDx for diagnostic assistance. What is your diagnosis? Based on what criteria? What further testing, if any, would you recommend?

Figure A


Figure C

Figure D

Figure E
Figure F

Figure G

Figure H
Figure I
Case Answer
This was a case of malaria caused by a dual infection with both Plasmodium falciparum and P. vivax. After the initial telediagnosis consultation, follow-up smears and EDTA blood were sent to the CDC-DPDx for further work-up.
In the initial specimen, only P. falciparum was identified by microscopy. The slides showed only ring-form trophozoites in normal-sized RBCs (Figures A-E). The rings were thin with delicate cytoplasm and several had double-chromatin dots (Figure B). Appliqué forms were also observed (Figures B, C, and E).
In the second specimen, only P. vivax was identified by microscopy. Figures F, H, and I showed pleomorphic gametocytes in enlarged infected RBCs with Schϋffner's stippling. Figure G showed a developing amoeboid trophozoite with a single, large chromatin dot in an enlarged infected RBC.
Conventional (nested) PCR was also performed on the EDTA blood for both collection dates. The initial collection date was positive for both species, however the second collection date was only positive for P. vivax. The most-likely scenario is that the patient had a dual infection initially, but the P. vivax was below the detection level for microscopy. After the patient was successfully treated for P. falciparum, the P. vivax relapsed from its dormant stage (hypnozoites) in the liver.
More on: Malaria
Images presented in the monthly case studies are from specimens submitted for diagnosis or archiving. On rare occasions, clinical histories given may be partly fictitious.
DPDx is an education resource designed for health professionals and laboratory scientists. For an overview including prevention and control visit www.cdc.gov/parasites/.
- Page last reviewed: August 24, 2016
- Page last updated: August 24, 2016
- Content source:
- Global Health – Division of Parasitic Diseases and Malaria
- Notice: Linking to a non-federal site does not constitute an endorsement by HHS, CDC or any of its employees of the sponsors or the information and products presented on the site.
- Maintained By:


 ShareCompartir
ShareCompartir